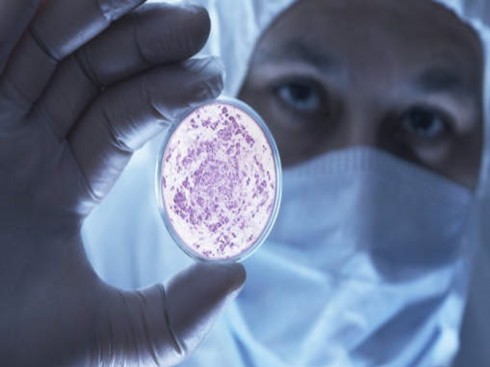

L'allarme degli esperti: aumento della listeriosi in Europa molto preoccupante.
Dettagli della notizia
Gli esperti scientifici dell’organismo europeo di vigilanza sulla sicurezza alimentare oggi hanno lanciato l'allarme sulla progressione delle forme mortali di listeriosi, compresa la malattia contratta mangiando gli alimenti.
In un parere pubblicato oggi, il Gruppo di esperti sui pericoli biologici (BIOHAZ) dell’Autorità europea per la sicurezza alimentare (EFSA) e del centro europeo per la prevenzione delle malattie (ECDC) ha concluso che tra il 2012 e il 2013, i casi di listeriosi sono aumentati dell' 8,6%, confermando una tendenza in forte crescita iniziata nel 2008 specialmente negli ultrasessantenni.
Nel parere rivolto in particolare ai produttori, il Gruppo ha inoltre riferito che gli Stati membri dell'UE hanno segnalato 1.763 casi nel 2013. Se questo numero non è allarmante di per sé, continua il rapporto, " le infezioni sono principalmente causa di malattia invasiva e di forme gravi che hanno più alti tassi di mortalità rispetto le altre malattie di origine alimentare".
Le morti segnalate sono state in totale 191, con un tasso di mortalità del 15,6% per questa zoonosi, malattia trasmessa all'uomo dagli animali, direttamente o tramite il cibo.
Secondo Mike Catchpole, direttore scientifico presso l'ECDC, l'aumento dei casi di listeriosi invasiva "è molto preoccupante perché questa infezione si trasmette principalmente attraverso i cibi pronti che permettono la crescita del batterio e ne sviluppano un’elevata concentrazione durante la catena alimentare. La Listeria può portare alla morte, specialmente tra la popolazione crescente di anziani e pazienti con immunità indebolita in Europa".
Invece i casi di Salmonella nell’uomo continuano a diminuire, facendo registrare un calo per l'ottavo anno consecutivo, con 82,694 casi (7,9%) grazie al successo dei programmi di controllo del pollame. Ora, osserva Giovanni D'Agata presidente dello “Sportello dei Diritti”, sentito il parere allarmante degli esperti, è necessario che gli sforzi per ridurre i rischi alla salute umana siano concentrati sulle pratiche di riduzione del rischio, sia nella fase di produzione dei cibi pronti al consumo, sia in casa da parte del consumatore. Pertanto si raccomanda a quest'ultimi di osservare senza interruzioni le temperature di conservazione consigliate e di mantenere i cibi sempre adeguatamente refrigerati, prendendo nota della scadenza dei cibi nel loro frigorifero. Una corretta igiene alimentare e l’adozione di buoni criteri di preparazione sono anch’esse fattori importanti nella prevenzione della Listeria e di altre infezioni di origine alimentare.
Si ricorda che la listeriosi è un’infezione di origine alimentare rara ma potenzialmente letale causata da Listeria monocytogenes e caratterizzata da un elevato tasso di mortalità. Le persone anziane e le donne in gravidanza sono particolarmente vulnerabili alla listeriosi, così come i soggetti affetti da patologie immunodepressive, come il cancro e l’HIV.